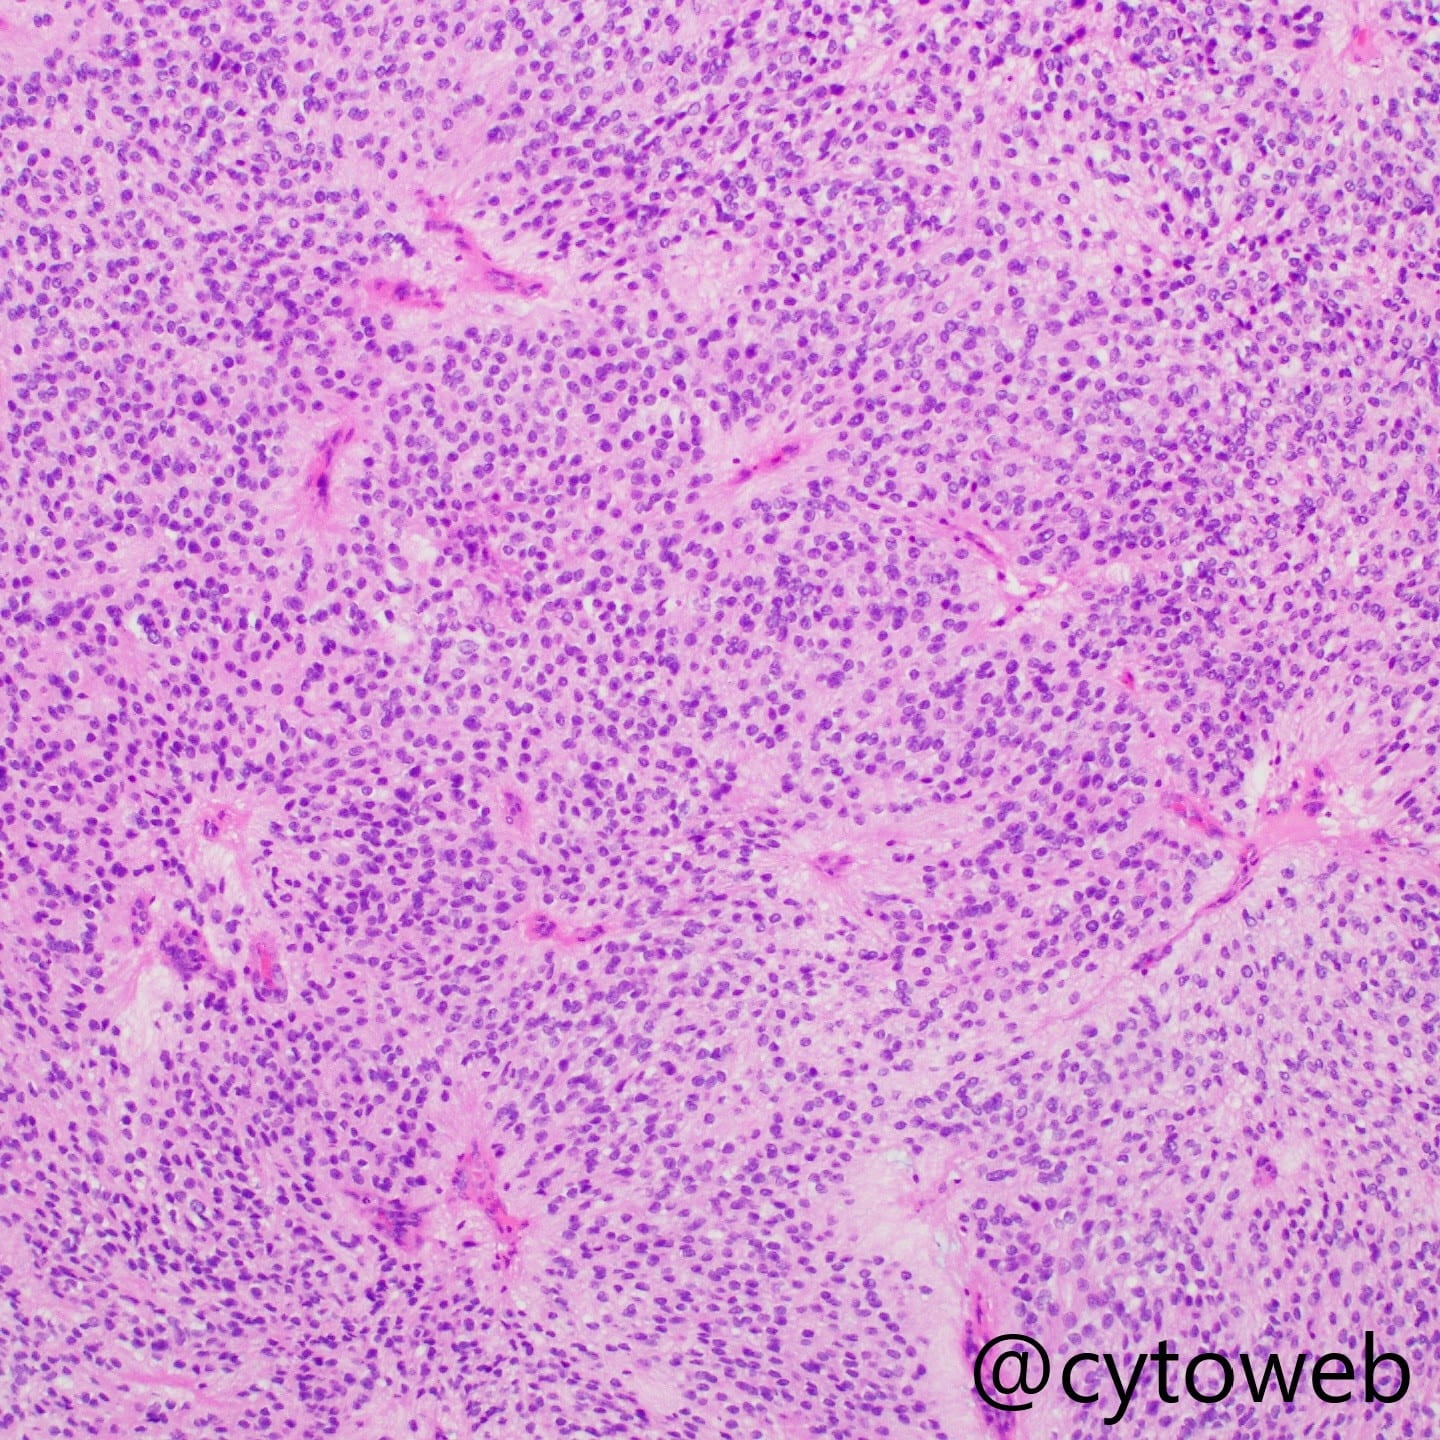

Here are some differential diagnoses based on the imaging findings:
- Intradural extramedullary spinal lesions
- Meningioma
- Uneven smears with large irregular clusters, small groups and single cells
- Cells display ovoid nuclei, fine chromatin, small nucleoli, nuclear pseudoinclusions, and abundant cytoplasm with broad borderless cytoplasmic processes
- Cells may be arranged in whorls
- +/- Psammoma bodies
- Schwannoma
- Clusters of spindle cells with slender, wavy nuclei associated with fibrillary stroma
- Nuclear palisading may be seen
- Generally lack single cells in the background
- Intradural intramedullary spinal lesions
- Ependymoma
- Fibrillary tissue fragments and discohesive sheets of small and uniform cells with round to ovoid nuclei and finely speckled chromatin
- Ependymal rosettes and perivascular pseudorosettes
- Others
- Metastatic tumour
- Morphology depends on the primary tumour
- Less likely given the young age and absence of previous history of malignancy
Reference: Lacruz C. R., et al. Central Nervous System Intraoperative Cytopathology. 2nd Edition. Springer International Publishing, 2018.